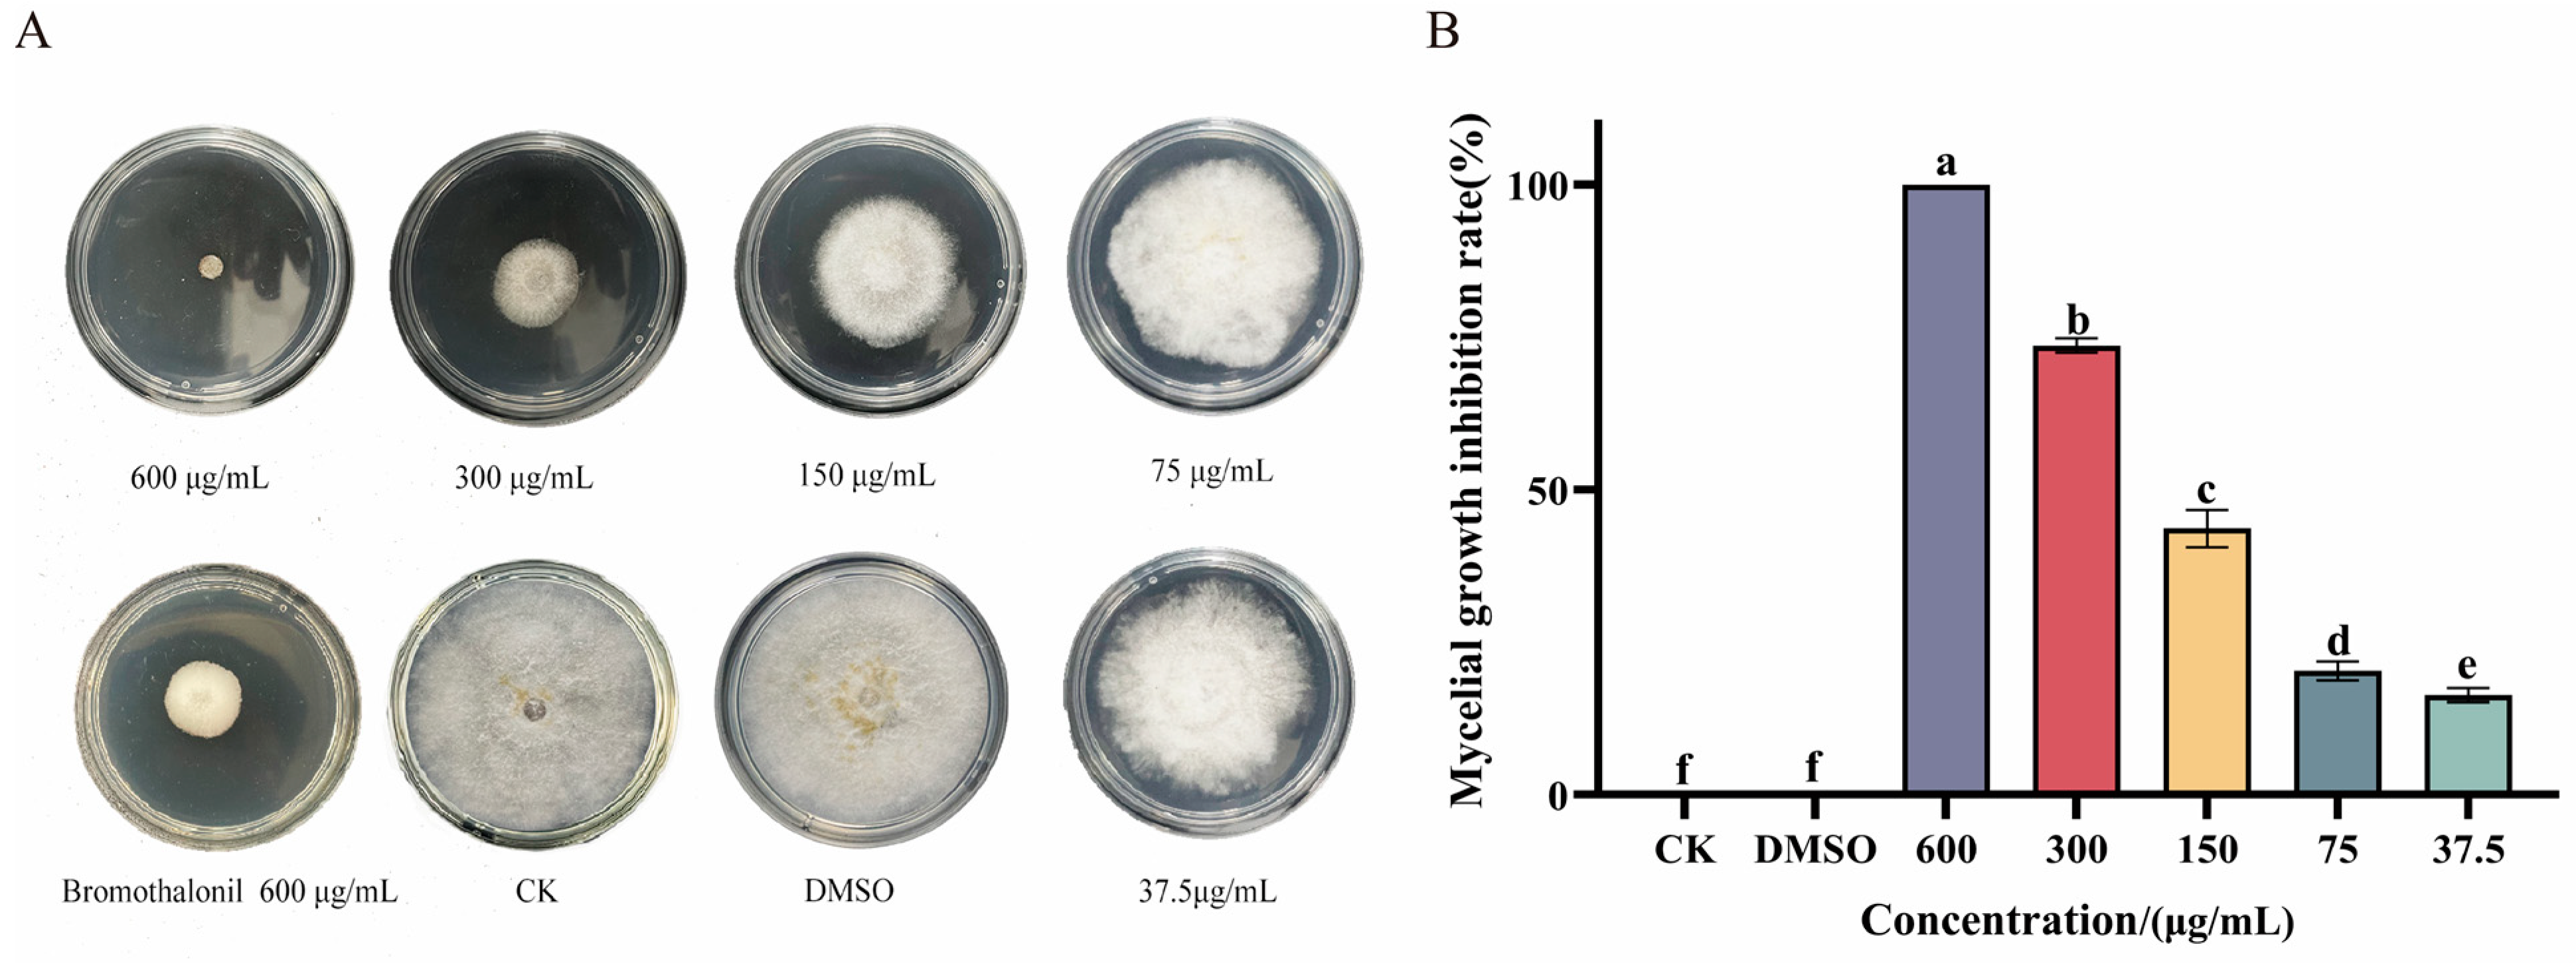
Jof 10 00488 g001

Antifungal Activity of Sesamol on Pestalotiopsis neglecta: Interfering with Cell Membrane and Energy Metabolism
Abstract
1. Introduction
2. Materials and Methods
2.1. Materials
2.2. Pathogens and Cultures
2.3. Inhibition of Mycelial Growth of P. neglecta by Ses
2.4. Scanning Electron Microscopy (SEM) and Transmission Electron Microscopy (TEM)
2.5. Determination of Ergosterol Content of P. neglecta Mycelium by Ses
2.6. Determination of Total Lipid Content of P. neglecta Mycelium by Ses
2.7. Determination of Cell Membrane Integrity
2.8. Determination of Cellular Content Leakage and pH Value
2.9. Measure of ATP Content and Key Enzyme Activities in the TCA Cycle
2.10. Determination of PG and EG Activities in P. neglecta
2.11. Data Analysis
3. Results
3.1. Ses Inhibits Mycelial Growth of P. neglecta
3.2. Ses Destroys Membrane Integrity of P. neglecta
3.3. Ses Alters the Morphology of P. neglecta
3.4. Impact of Ses on Ergosterol and Total Lipid Content in P. neglecta
3.5. Leakage of Cell Constituents after Ses Treatment
3.6. Effect of Ses on ATP Content and Key Enzyme Activities in the TCA Cycle
3.7. Ses Inhibits PG and EG Activities of P. neglecta
4. Discussion
5. Conclusions
Author Contributions
Funding
Institutional Review Board Statement
Informed Consent Statement
Data Availability Statement
Conflicts of Interest
Abbreviations
References
- Chen, J.; Hao, X.; Liu, X.; Ma, L. First Report of Pestalotiopsis neglecta Causing Black Spot Needle Blight of Pinus sylvestris var. mongolica in China. Plant Dis. 2020, 104, 1545. [Google Scholar] [CrossRef]
- Yang, J.; Wang, S.R.; Zhang, Y.D.; Chen, Y.Z.; Zhou, H.Y.; Zhang, G.C. Identification, Culture Characteristics and Whole-Genome Analysis of Pestalotiopsis neglecta Causing Black Spot Blight of Pinus sylvestris var. mongolica. J. Fungi 2023, 9, 564. [Google Scholar] [CrossRef] [PubMed]
- Zhang, Y.D.; Yang, J.; Wang, S.R.; Chen, Y.Z.; Zhang, G.C. TMT-Based Proteomic Analysis Reveals the Molecular Mechanisms of Sodium Pheophorbide A against Black Spot Needle Blight Caused by Pestalotiopsis neglecta in Pinus sylvestris var. mongolica. J. Fungi 2024, 10, 102. [Google Scholar] [CrossRef] [PubMed]
- Deresa, E.M.; Diriba, T.F. Phytochemicals as alternative fungicides for controlling plant diseases: A comprehensive review of their efficacy, commercial representatives, advantages, challenges for adoption, and possible solutions. Heliyon 2023, 9, e13810. [Google Scholar] [CrossRef] [PubMed]
- Matrose, N.A.; Obikeze, K.; Belay, Z.A.; Caleb, O.J. Plant extracts and other natural compounds as alternatives for post-harvest management of fruit fungal pathogens: A review. Food Biosci. 2021, 41, 100840. [Google Scholar] [CrossRef]
- Nasim, N.; Sandeep, I.S.; Mohanty, S. Plant-derived natural products for drug discovery: Current approaches and prospects. Nucleus 2022, 65, 399–411. [Google Scholar] [CrossRef] [PubMed]
- Abad, M. Active antifungal substances from natural sources. Arkivoc 2007, 7, 116–145. [Google Scholar] [CrossRef]
- Ansari, M.; Anurag, A.; Fatima, Z.; Hameed, S. Natural phenolic compounds: A potential antifungal agent. Microb. Pathog. Strateg. Combat. Them. Sci. Technol. Educ. 2013, 1, 1189–1195. [Google Scholar]
- Zabka, M.; Pavela, R. Antifungal efficacy of some natural phenolic compounds against significant pathogenic and toxinogenic filamentous fungi. Chemosphere 2013, 93, 1051–1056. [Google Scholar] [CrossRef] [PubMed]
- Wang, C.; Zhang, J.; Chen, H.; Fan, Y.; Shi, Z. Antifungal activity of eugenol against Botrytis cinerea. Trop. Plant Pathol. 2010, 35, 137–143. [Google Scholar] [CrossRef]
- Campaniello, D.; Corbo, M.R.; Sinigaglia, M. Antifungal Activity of Eugenol against Penicillium, Aspergillus, and Fusarium Species. J. Food Prot. 2010, 73, 1124–1128. [Google Scholar] [CrossRef] [PubMed]
- Mączka, W.; Twardawska, M.; Grabarczyk, M.; Wińska, K. Carvacrol—A Natural Phenolic Compound with Antimicrobial Properties. Antibiotics 2023, 12, 824. [Google Scholar] [CrossRef] [PubMed]
- Wang, K.; Jiang, S.; Pu, T.; Fan, L.; Su, F.; Ye, M. Antifungal activity of phenolic monoterpenes and structure-related compounds against plant pathogenic fungi. Nat. Prod. Res. 2019, 33, 1423–1430. [Google Scholar] [CrossRef]
- Zhang, J.; Ma, S.; Du, S.; Chen, S.; Sun, H. Antifungal activity of thymol and carvacrol against postharvest pathogens Botrytis cinerea. J. Food Sci. Technol. 2019, 56, 2611–2620. [Google Scholar] [CrossRef] [PubMed]
- Kong, J.; Zhang, Y.; Ju, J.; Xie, Y.; Guo, Y.; Cheng, Y.; Qian, H.; Quek, S.Y.; Yao, W. Antifungal effects of thymol and salicylic acid on cell membrane and mitochondria of Rhizopus stolonifer and their application in postharvest preservation of tomatoes. Food Chem. 2019, 285, 380–388. [Google Scholar] [CrossRef] [PubMed]
- Ansari, M.A.; Fatima, Z.; Hameed, S. Mechanistic insights into the mode of action of anticandidal sesamol. Microb. Pathog. 2016, 98, 140–148. [Google Scholar] [CrossRef] [PubMed]
- Hans, S.; Sharma, S.; Hameed, S.; Fatima, Z. Sesamol exhibits potent antimycobacterial activity: Underlying mechanisms and impact on virulence traits. J. Glob. Antimicrob. Resist. 2017, 10, 228–237. [Google Scholar] [CrossRef] [PubMed]
- Avis, T.J. Antifungal compounds that target fungal membranes: Applications in plant disease control. Can. J. Plant Pathol. 2007, 29, 323–329. [Google Scholar] [CrossRef]
- Li, Y.; Guo, L.; Zhou, Z. Exploring the antifungal mechanism of limonin-loaded eugenol emulsion against Penicillium italicum: From the perspective of microbial metabolism. Postharvest Biol. Technol. 2021, 182, 111704. [Google Scholar] [CrossRef]
- Paul, S.; Dubey, R.C.; Maheswari, D.K.; Kang, S.C. Trachyspermum ammi (L.) fruit essential oil influencing on membrane permeability and surface characteristics in inhibiting food-borne pathogens. Food Control 2011, 22, 725–731. [Google Scholar] [CrossRef]
- Ma, W.; Zhao, L.; Zhao, W.; Xie, Y. (E)-2-Hexenal, as a Potential Natural Antifungal Compound, Inhibits Aspergillus flavus Spore Germination by Disrupting Mitochondrial Energy Metabolism. J. Agric. Food Chem. 2019, 67, 1138–1145. [Google Scholar] [CrossRef] [PubMed]
- Li, N.; Wu, Y.-X.; Zhang, Y.-D.; Wang, S.-R.; Zhang, G.-C.; Yang, J. Phytic acid is a new substitutable plant-derived antifungal agent for the seedling blight of Pinus sylvestris var. mongolica caused by Fusarium oxysporum. Pestic. Biochem. Physiol. 2023, 191, 105341. [Google Scholar]
- Furlaneto, M.C.; de Jesus Andrade, C.G.T.; Furlaneto-Maia, L.; de França, E.J.G.; Moralez, A.T.P. Pathogenic Attributes of Non-Candida albicans Candida Species Revealed by SEM. In Scanning Electron Microscopy; Kazmiruk, V., Ed.; IntechOpen: Rijeka, Croatia, 2012; pp. 295–313. [Google Scholar]
- Zhan, L.; Tian, X.; Lin, J.; Zhang, Y.; Zheng, H.; Peng, X.; Zhao, G. Honokiol reduces fungal burden and ameliorate inflammation lesions of Aspergillus fumigatus keratitis via Dectin-2 down-regulation. Int. Immunopharmacol. 2023, 118, 109849. [Google Scholar] [CrossRef]
- Chen, J.; Wu, L.; Lu, M.; Lu, S.; Li, Z.; Ding, W. Comparative Study on the Fungicidal Activity of Metallic MgO Nanoparticles and Macroscale MgO Against Soilborne Fungal Phytopathogens. Front. Microbiol. 2020, 11, 365. [Google Scholar] [CrossRef] [PubMed]
- Hamada, S.; Rauz, S. Microbiology, virology and histopathological sampling and diagnosis. In Diagnostic Technologies in Ophthalmology; Bentham Science Publishers: Sharjah, United Arab Emirates, 2012; pp. 50–90. [Google Scholar]
- He, L.; Liu, Y.; Mustapha, A.; Lin, M. Antifungal activity of zinc oxide nanoparticles against Botrytis cinerea and Penicillium expansum. Microbiol. Res. 2011, 166, 207–215. [Google Scholar] [CrossRef]
- Xia, Z.K.; Ma, Q.H.; Li, S.Y.; Zhang, D.Q.; Cong, L.; Tian, Y.L.; Yang, R.Y. The antifungal effect of silver nanoparticles on Trichosporon asahii. J. Microbiol. Immunol. Infect. 2016, 49, 182–188. [Google Scholar] [CrossRef] [PubMed]
- Zeng, H.; Chen, X.; Liang, J. In vitro antifungal activity and mechanism of essential oil from fennel (Foeniculum vulgare L.) on dermatophyte species. J. Med. Microbiol. 2015, 64, 93–103. [Google Scholar] [CrossRef]
- Li, Q.; Zhu, X.; Zhao, Y.; Xie, Y. The antifungal activity of o-vanillin against Aspergillus flavus via disrupting ergosterol biosynthesis and promoting oxidative stress, and an RNA-seq analysis thereof. LWT 2022, 164, 113635. [Google Scholar] [CrossRef]
- Elsherbiny, E.A.; Dawood, D.H.; Safwat, N.A. Antifungal action and induction of resistance by β-aminobutyric acid against Penicillium digitatum to control green mold in orange fruit. Pestic. Biochem. Physiol. 2021, 171, 104721. [Google Scholar] [CrossRef] [PubMed]
- Patel, A.; Antonopoulou, I.; Enman, J.; Rova, U.; Christakopoulos, P.; Matsakas, L. Lipids detection and quantification in oleaginous microorganisms: An overview of the current state of the art. BMC Chem. Eng. 2019, 1, 13. [Google Scholar] [CrossRef]
- Li, Q.; Zhu, X.; Xie, Y.; Zhong, Y. o-Vanillin, a promising antifungal agent, inhibits Aspergillus flavus by disrupting the integrity of cell walls and cell membranes. Appl. Microbiol. Biotechnol. 2021, 105, 5147–5158. [Google Scholar] [CrossRef]
- Yan, H.; Meng, X.; Lin, X.; Duan, N.; Wang, Z.; Wu, S. Antifungal activity and inhibitory mechanisms of ferulic acid against the growth of Fusarium graminearum. Food Biosci. 2023, 52, 102414. [Google Scholar] [CrossRef]
- Liu, L.; Jin, X.; Lu, X.; Guo, L.; Lu, P.; Yu, H.; Lv, B. Mechanisms of Surfactin from Bacillus subtilis SF1 against Fusarium foetens: A Novel Pathogen Inducing Potato Wilt. J. Fungi 2023, 9, 367. [Google Scholar] [CrossRef] [PubMed]
- Li, Q.; Zhu, X.; Xie, Y.; Ren, S. 2-Hydroxy-4-methoxybenzaldehyde inhibits the growth of Aspergillus flavus via damaging cell wall, cell membrane, manipulating respiration thus creating a promising antifungal effect on corn kernels. Int. J. Food Sci. Technol. 2021, 56, 178–184. [Google Scholar] [CrossRef]
- Zhang, Y.; Li, T.; Xu, M.; Guo, J.; Zhang, C.; Feng, Z.; Peng, X.; Li, Z.; Xing, K.; Qin, S. Antifungal effect of volatile organic compounds produced by Pseudomonas chlororaphis subsp. aureofaciens SPS-41 on oxidative stress and mitochondrial dysfunction of Ceratocystis fimbriata. Pestic. Biochem. Physiol. 2021, 173, 104777. [Google Scholar]
- Rashad, Y.; Aseel, D.; Hammad, S. Phenolic Compounds Against Fungal and Viral Plant Diseases. In Plant Phenolics in Sustainable Agriculture; Lone, R., Shuab, R., Kamili, A., Eds.; Springer: Singapore, 2020; pp. 201–219. [Google Scholar]
- Sun, S.; Tang, N.; Han, K.; You, J.; Liu, A.; Wang, Q.; Xu, Q. Antifungal Activity and Mechanism of 4-Propylphenol Against Fusarium graminearum, Agent of Wheat Scab, and Its Potential Application. J. Agric. Food Chem. 2024, 72, 5258–5268. [Google Scholar] [CrossRef] [PubMed]
- Zou, X.; Wei, Y.; Jiang, S.; Xu, F.; Wang, H.; Zhan, P.; Shao, X. ROS Stress and Cell Membrane Disruption are the Main Antifungal Mechanisms of 2-Phenylethanol against Botrytis cinerea. J. Agric. Food Chem. 2022, 70, 14468–14479. [Google Scholar] [CrossRef] [PubMed]
- Pan, J.; Hu, C.; Yu, J.H. Lipid Biosynthesis as an Antifungal Target. J. Fungi 2018, 4, 50. [Google Scholar] [CrossRef]
- Parks, L.W.; Casey, W.M. Physiological implications of sterol biosynthesis in yeast. Annu. Rev. Microbiol. 1995, 49, 95–116. [Google Scholar] [CrossRef] [PubMed]
- Cox, S.D.; Mann, C.M.; Markham, J.L.; Gustafson, J.E.; Warmington, J.R.; Wyllie, S.G. Determining the Antimicrobial Actions of Tea Tree Oil. Molecules 2001, 6, 87–91. [Google Scholar] [CrossRef]
- Mi, T.; Luo, D.; Li, J.; Qu, G.; Sun, Y.; Cao, S. Carvacrol exhibits direct antifungal activity against stem-end rot disease and induces disease resistance to stem-end rot disease in kiwifruit. Physiol. Mol. Plant Pathol. 2023, 127, 102065. [Google Scholar] [CrossRef]
- Ye, S.; Shuai, L.; Luo, D.; Ba, L. Inhibitory Activity and Mechanism of Action with Thymol against the Blueberry Pathogenic Fungi Caused by Neopestalotiopsis clavispora. Horticulturae 2023, 9, 983. [Google Scholar] [CrossRef]
- Martínez-Reyes, I.; Chandel, N.S. Mitochondrial TCA cycle metabolites control physiology and disease. Nat. Commun. 2020, 11, 102. [Google Scholar] [CrossRef] [PubMed]
- Liu, M.; Feng, M.; Yang, K.; Cao, Y.; Zhang, J.; Xu, J.; Hernández, S.H.; Wei, X.; Fan, M. Transcriptomic and metabolomic analyses reveal antibacterial mechanism of astringent persimmon tannin against Methicillin-resistant Staphylococcus aureus isolated from pork. Food Chem. 2020, 309, 125692. [Google Scholar] [CrossRef] [PubMed]
- Yang, J.; Ji, J.Y.; Zhang, B.W.; Chen, Y.Z.; Wang, S.R.; Zhang, G.C.; Zhang, J. Transcriptome and cell wall degrading enzyme-related gene analysis of Pestalotiopsis neglecta in response to sodium pheophorbide a. Pestic. Biochem. Physiol. 2020, 169, 104639. [Google Scholar] [CrossRef] [PubMed]
- Kars, I.; Krooshof, G.H.; Wagemakers, L.; Joosten, R.; Benen, J.A.; van Kan, J.A. Necrotizing activity of five Botrytis cinerea endopolygalacturonases produced in Pichia pastoris. Plant J. 2005, 43, 213–225. [Google Scholar] [CrossRef] [PubMed]
- Ma, L.; Liu, T.; Zhang, K.; Shi, H.; Zhang, L.; Zou, G.; Sharon, A. Botrytis cinerea Transcription Factor BcXyr1 Regulates (Hemi-)Cellulase Production and Fungal Virulence. mSystems 2022, 7, e0104222. [Google Scholar] [CrossRef] [PubMed]
- Paccanaro, M.C.; Sella, L.; Castiglioni, C.; Giacomello, F.; Martínez-Rocha, A.L.; D’Ovidio, R.; Schäfer, W.; Favaron, F. Synergistic Effect of Different Plant Cell Wall-Degrading Enzymes Is Important for Virulence of Fusarium graminearum. Mol. Plant Microbe Interact. 2017, 30, 886–895. [Google Scholar] [CrossRef] [PubMed]
- Ranjbar, A.; Ramezanian, A.; Shekarforoush, S.; Niakousari, M.; Eshghi, S. Antifungal activity of thymol against the main fungi causing pomegranate fruit rot by suppressing the activity of cell wall degrading enzymes. LWT 2022, 161, 113303. [Google Scholar] [CrossRef]

| Phytopathogenic | EC50 (µg/mL) | 95% Confidence Interval (µg/mL) | Correlation Coefficient | Toxicity Equation | |
|---|---|---|---|---|---|
| Ses | P. neglecta | 142.02 ± 13.22 | 118.59~170.42 | 0.927 | Y = 1.83x − 4.05 |
Disclaimer/Publisher’s Note: The statements, opinions and data contained in all publications are solely those of the individual author(s) and contributor(s) and not of MDPI and/or the editor(s). MDPI and/or the editor(s) disclaim responsibility for any injury to people or property resulting from any ideas, methods, instructions or products referred to in the content. |
© 2024 by the authors. Licensee MDPI, Basel, Switzerland. This article is an open access article distributed under the terms and conditions of the Creative Commons Attribution (CC BY) license (https://creativecommons.org/licenses/by/4.0/).
Share and Cite
Ma, W.; Ji, J.; Zhang, B.; Sun, W.; Zhao, J.; Zhang, J.; Zhang, G. Antifungal Activity of Sesamol on Pestalotiopsis neglecta: Interfering with Cell Membrane and Energy Metabolism. J. Fungi 2024, 10, 488. https://doi.org/10.3390/jof10070488
Ma W, Ji J, Zhang B, Sun W, Zhao J, Zhang J, Zhang G. Antifungal Activity of Sesamol on Pestalotiopsis neglecta: Interfering with Cell Membrane and Energy Metabolism. Journal of Fungi. 2024; 10(7):488. https://doi.org/10.3390/jof10070488
Chicago/Turabian StyleMa, Weihu, Jingyu Ji, Bowen Zhang, Wenzhuo Sun, Jinyan Zhao, Jie Zhang, and Guocai Zhang. 2024. "Antifungal Activity of Sesamol on Pestalotiopsis neglecta: Interfering with Cell Membrane and Energy Metabolism" Journal of Fungi 10, no. 7: 488. https://doi.org/10.3390/jof10070488
APA StyleMa, W., Ji, J., Zhang, B., Sun, W., Zhao, J., Zhang, J., & Zhang, G. (2024). Antifungal Activity of Sesamol on Pestalotiopsis neglecta: Interfering with Cell Membrane and Energy Metabolism. Journal of Fungi, 10(7), 488. https://doi.org/10.3390/jof10070488





